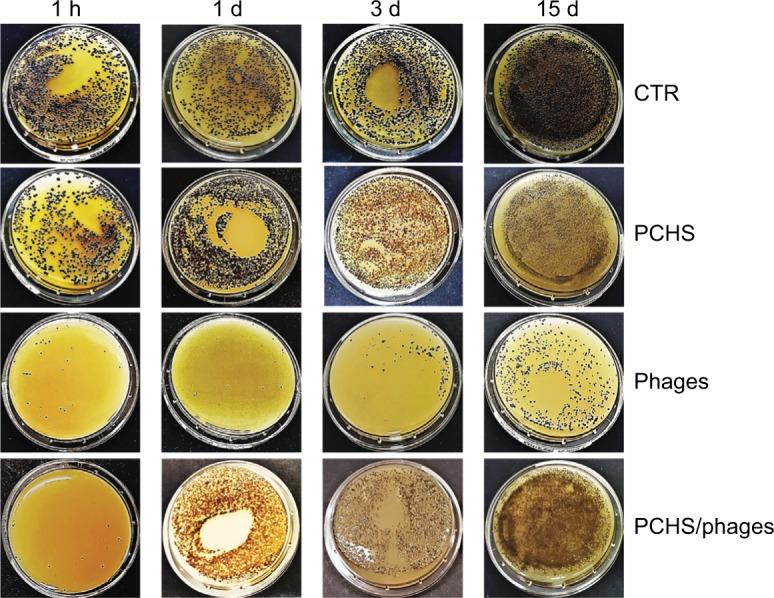
https://cdn.ncbi.nlm.nih.gov/pmc/blobs/4652/6071622/663b1d7ebfe7/idr-11-1015Fig5.jpg

通过联合使用噬菌体和益生菌从硬表面高效去除医院病原体:作为消毒剂的潜力。
Efficient removal of hospital pathogens from hard surfaces by a combined use of bacteriophages and probiotics: potential as sanitizing agents.
作者信息
D'Accolti Maria, Soffritti Irene, Piffanelli Micol, Bisi Matteo, Mazzacane Sante, Caselli Elisabetta
机构信息
CIAS Interdepartmental Centre, Department of Medical Sciences, University of Ferrara, Ferrara, Italy,
Section of Microbiology, Department of Medical Sciences, University of Ferrara, Ferrara, Italy,
出版信息
Infect Drug Resist. 2018 Jul 30;11:1015-1026. doi: 10.2147/IDR.S170071. eCollection 2018.
PURPOSE
Many hospital-acquired infections (HAIs) can be transmitted by pathogens contaminating hospital surfaces, not efficiently controlled by conventional sanitation, which can indeed contribute to the selection of MDR strains. Bacteriophages have been suggested as decontaminating agents, based on their selective ability to kill specific bacteria. However, there are no data on their stability in detergents and their potential use in routine sanitation. On the other hand, a probiotic-based sanitation system (Probiotic Cleaning Hygiene System, PCHS) was recently shown to stably reduce pathogens on treated surfaces. However, its action is not specific and slow, being based on competitive antagonism. This work aimed to assess the effectiveness of a combined use of phages and PCHS in removing HAI-associated pathogens from different hard surfaces.
MATERIALS AND METHODS
The decontamination ability of phages in PCHS was tested in vitro and in situ, against drug-susceptible or resistant , , and strains, and using bacterial densities similar to those detected on hospital surfaces.
RESULTS
Phages targeted efficiently all tested bacteria, maintaining their full activity when added to the PCHS detergent. Notably, the combined use of phages and PCHS not only resulted in a rapid reduction (up to >90%) of the targeted pathogens, but also, due to the stabilizing effect of probiotics, the pathogens were maintained at low levels (>99%) at later times too, when instead the effect of phages tends to diminish.
CONCLUSION
These results suggest that a combined biological system might be successfully used in hospital sanitation protocols, potentially leading to effective and safe elimination of MDR pathogens from the hospital environment.
目的
许多医院获得性感染(HAIs)可通过污染医院表面的病原体传播,传统卫生措施无法有效控制这些病原体,这实际上可能有助于多重耐药菌株的产生。基于噬菌体对特定细菌的选择性杀伤能力,有人提出将其作为去污剂。然而,关于它们在洗涤剂中的稳定性及其在常规卫生中的潜在用途尚无数据。另一方面,最近有研究表明,基于益生菌的卫生系统(益生菌清洁卫生系统,PCHS)能稳定地减少处理过的表面上的病原体。然而,其作用不具有特异性且缓慢,基于竞争性拮抗作用。这项工作旨在评估噬菌体与PCHS联合使用在去除不同硬表面上与HAIs相关病原体方面的有效性。
材料与方法
在体外和原位测试了噬菌体在PCHS中的去污能力,针对药敏或耐药的 、 、 和 菌株,并使用与在医院表面检测到的细菌密度相似的细菌密度。
结果
噬菌体能有效靶向所有测试细菌,当添加到PCHS洗涤剂中时保持其全部活性。值得注意的是,噬菌体与PCHS联合使用不仅能使目标病原体迅速减少(高达>90%),而且由于益生菌的稳定作用,在后期病原体也能维持在低水平(>99%),而此时噬菌体的作用往往会减弱。
结论
这些结果表明,一种联合生物系统可能成功用于医院卫生规程,有可能有效且安全地从医院环境中消除多重耐药病原体。